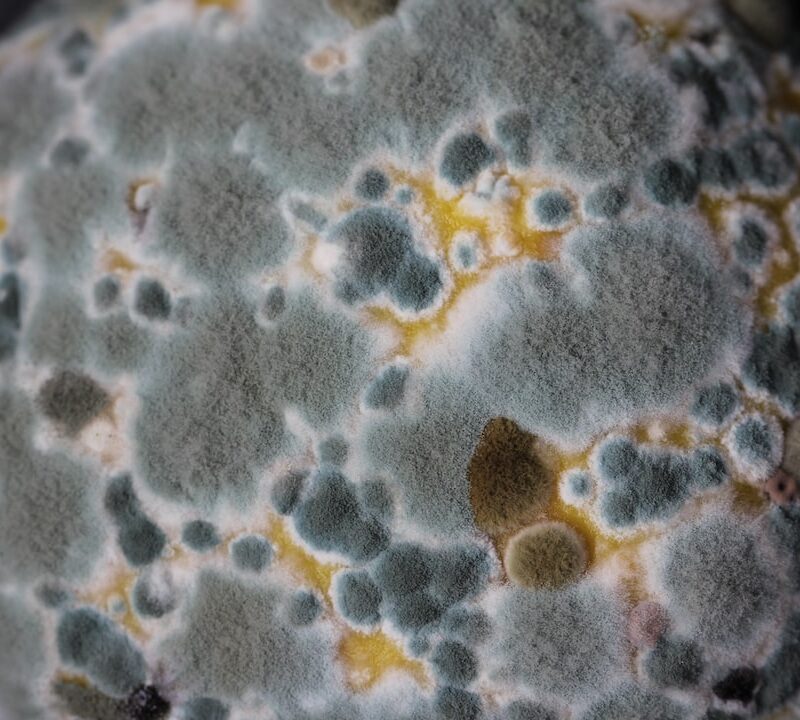

Homeowners looking to sell their property should consider getting their mold issues resolved. Having a professional mold remediation company care for the problem can save them money in the long run.
Buyers will be more willing to pay for a home that doesn’t have mold problems. They may even request that the seller pay for remediation.
Eliminate the Toxins
Molds release toxins called mycotoxins that are inhaled and swallowed. Mycotoxins hijack your immune system and leave you vulnerable to infection. They can also cause debilitating symptoms like brain fog, fatigue, and gastrointestinal issues. If gene mutations make it difficult to produce antibodies (like autoimmune conditions or cancer treatment), your body will be particularly susceptible to mycotoxins from toxic mold.
Mold spores are everywhere in nature, speeding up the decomposition of dead plants and trees, and they’re also found in food (including cereal grains, nuts, coffee, and bulk foods bought from bins to save money). Eventually, mold spores will find their way into your home if you live in an area with high humidity. Long-term exposure to toxic mold can also cause serious health problems, including gastrointestinal issues, memory loss, headaches, fatigue, and difficulty concentrating. Hiring a professional mold removal company will help you avoid these negative side effects.
Restore Your Home’s Appearance
In addition to causing health issues, mold spores can also deteriorate the surfaces of your home. When left untreated, this can lead to expensive structural damage. Mold professionals can restore and repair the areas affected by mold and help prevent it from reoccurring. They can also offer recommendations for preventing future problems, such as leaky pipes and inadequate ventilation. If you have a serious mold problem, acting quickly is important. Mold spores can spread rapidly and may be difficult to remove completely. When cleaning impacted areas, it’s also important to use proper safety equipment, such as respirators and gloves. The very act of cleaning mold can disturb the spores and cause them to circulate throughout your home, which can be dangerous for people with compromised immune systems. Inhaling mold spores can even cause respiratory problems in healthy people. Having a professional handle the mold remediation process will ensure your family is safe and can enjoy a clean, beautiful home.
Save Money in the Long Run
The longer a mold problem goes unchecked, the worse it will get. It can sometimes cause drywall and ceilings to crumble or even collapse. Locating and remediating mold early on can prevent such severe damage. A professional mold inspection company will have the right equipment for hard-to-reach areas, such as HVAC ductwork or behind walls. They will also have the necessary tools to clean the area and remove any affected items. They will have the equipment to identify where moisture is present, too. Moisture is the primary driver of most mold problems, so eliminating it can help prevent future growth. When hiring a professional mold inspection and remediation company, look for one that charges reasonable prices, doesn’t push unnecessary testing, and can explain the process in plain English. Ideally, they will have experience dealing with different kinds of mold and use their expertise to provide the best solutions for your home.
Avoid Further Damage
Mold spores need moisture to grow. Once they find a damp surface, they multiply and spread quickly. That’s why it’s important to immediately address any sign of mold and act quickly when it happens. The longer you wait to tackle a mold problem, the more extensive the damage will be and the more money it will cost to repair it. Mold professionals know how to spot even the most hidden signs of mold growth. They also have special tools and air scrubbers that are far more effective than anything you can buy at a home improvement store. They can seal off the work area and replace dirty moldy air with clean, fresh air to prevent airborne spores from spreading throughout the home.
Mold inspectors can even assess places difficult for homeowners to reach, such as behind walls, inside flooring or ceiling tubes and underneath appliances. They can also ensure that the problem won’t return by identifying and fixing the source of the moisture infiltration.